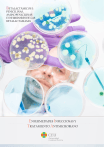

- No category
Antibióticos Betalactámicos: Penicilinas e Inhibidores
advertisement
BETALACTÁMICOS I: PENICILINAS, AMINOPENICILINAS E INHIBIDORES DE LAS BETALACTAMASAS ÍNDICE 01 Introducción . . . . . . . . . . . . . . . . . . . . . . . . pág. 01 02 Clasificación de los antibióticos betalactámicos: penicilinas . . pág. 02 03 Espectro de acción bacteriano . . . . . . . . . . . . . . . . pág. 02 04 Mecanismos de acción de los antibióticos betalactámicos . . . pág. 04 05 Indicaciones clínicas . . . . . . . . . . . . . . . . . . . . . pág. 05 5.1. Penicilinas de primera generación 5.2. Penicilinas con acción antiestafilocócica 5.3. Aminopenicilinas 5.4. Carboxipenicilinas y Ureidopenicilinas 06 Posología de las diferentes penicilinas . . . . . . . . . . . . pág. 08 07 Mecanismos de resistencias bacteriana . . . . . . . . . . . . pág. 09 7.1. Betalactamasas 7.2. Impermeabilización de la membrana bacteriana 7.3. Mecanismo de expulsión 7.4. PBP de baja afinidad por los betalactámicos 08 Efectos secundarios . . . . . . . . . . . . . . . . . . . . . pág. 11 8.1. Reacciones de hipersensibilidad 8.2. Reacciones cruzadas 09 Bibliografía . . . . . . . . . . . . . . . . . . . . . . . . pág. 14 AutorA: Adriana Hernández Belmonte BETALACTÁMICOS I: PENICILINAS, AMINOPENICILINAS E INHIBIDORES DE LAS BETALACTAMASAS 01 INTRODUCCIÓN Los antibióticos betalactámicos constituyen, por su número y relevancia clínica, el grupo más importante de antibióticos. Fue Fleming el que observó el efecto destructivo del hongo filamentoso Penicillium sobre las bacterias de la placa de cultivo en 1928, pero fueron los estudios de Florey y Chain, en la década de los 40 del siglo XX, los que permitieron la producción comercial de penicilina de manera que pudiera ser útil en la atención clínica de seres humanos. Se puede afirmar que el empleo de la penicilina y de los antibióticos betalactámicos, que desde entonces se han ido sintetizando, constituyen un hito crucial en la historia de la Humanidad y un gran paso para el desarrollo de otras disciplinas de la Medicina, como la cirugía o los trasplantes. Los antibióticos betalactámicos presentan como característica común la presencia del denominado anillo betalactámico, constituido por la condensación de alanina y betadimetilcisteína. La naturaleza de los radicales esenciales que se unen al anillo betalactámico definen las diferentes clases de antibióticos betalactámicos. Las cadenas laterales complementan las características antimicrobianas y farmacocinéticas y son la causa de los efectos adversos. Figura 1. Estructura de los antibióticos betalactámicos. ENFERMEDADES INFECCIOSAS Y TRATAMIENTO ANTIMICROBIANO 1 BETALACTÁMICOS I: PENICILINAS, AMINOPENICILINAS E INHIBIDORES DE LAS BETALACTAMASAS 02 CLASIFICACIÓN DE LOS ANTIBIÓTICOS BETALACTÁMICOS; PENICILINAS Los antibióticos betalactámicos se pueden clasificar en cuatro grandes grupos: penicilinas, cefalosporinas, carbapenemes y monobactámicos. En este primer tema, dedicado a los antibióticos betalactámicos, únicamente se tratarán las penicilinas. Las penicilinas se pueden dividir en cinco subgrupos, según su espectro de acción, aunque existe cierta superposición entre los mismos. • Bencilpeniclinas (penicilinas de primera generación): Bencilpenicilina-penicilina G (parenteral), Fenoximetilpenicilina-penicilina V (oral). • Isoxazolilpenicilinas (penicilinas semisintéticas): Cloxacilina (oral/parenteral), Oxazolina (no uso clínico), Meticilina (no uso clínico). • Aminopenicilinas: Amoxicilina (oral/parenteral), Ampicilina (oral/parenteral). • Carboxipenicilinas: Ticarcilina (parenteral). • Ureidopenicilinas: Piperacilina (parenteral). Existen también Penicilinas combinadas con inhibidores de betalactamasas: Amoxicilinaácido clavulánico (oral/parenteral), Ampicilina-sulbactam (parenteral), Piperacilinatazobactam (parenteral). 03 ESPECTRO DE ACCIÓN BACTERIANO Las penicilinas de primera generación tienen actividad, preferentemente, frente a bacterias grampositivas no productoras de betalactamasas, bacterias anaerobias y algunos cocos gramnegativos (principalmente, meningococo). Las penicilinas semisintéticas resistentes a penicilinasas, son el tratamiento de elección frente a Staphylococcus Aureus sensible a penicilinas y estafilococos coagulasa negativos también sensibles. Este grupo presenta actividad frente a estreptococos (no así, frente a enterococos), pero no es su tratamiento de elección. Las aminopenicilinas presentan un espectro de acción similar al de las penicilinas de primera generación y además, amplían el espectro de acción frente a otros cocos gramnegativos y frente a enterobacterias que no producen betalactamasas. Éste es, además, el grupo de antibióticos betalactámicos que presenta una mayor actividad frente a enterococos sensibles a penicilinas. ENFERMEDADES INFECCIOSAS Y TRATAMIENTO ANTIMICROBIANO 2 BETALACTÁMICOS I: PENICILINAS, AMINOPENICILINAS E INHIBIDORES DE LAS BETALACTAMASAS El cuarto grupo es el de las denominadas carboxipenicilinas y el quinto el de las Ureidopenicilinas; estos dos grupos presentan la característica de ampliar el espectro frente a bacilos gramnegativos aerobios, de los cuales, el más importante a tener en cuenta es Pseudomonas Aeruginosa. La mayoría de las bacterias anaerobias grampositivas son sensibles a las penicilinas, al igual que la mayoría de las bacterias anaerobias gramnegativas (salvo algunas excepciones importantes, como Bacteroides fragilis, que produce una betalactamasa). Combinaciones con inhibidores de betalactamasas. Algunas de las bacterias son productoras de una enzima denominada betalactamasa, capaz de romper el anillo betalactámico de las penicilinas y por tanto, ser resistentes a su acción. Los inhibidores de betalactamasas tienen poca actividad antibacteriana intrínseca, pero inhiben la actividad de un número de betalactamasas mediadas por plásmidos. Existe la posibilidad de combinar una penicilina con un inhibidor de betalactamasas, de modo que el antibiótico sea activo frente a las bacterias productoras de esta enzima. Las combinaciones más importantes desde el punto de vista clínico son: Amoxicilina con ácido clavulánico, ampicilina con sulbactam y piperacilina con tazobactam. Estas combinaciones son necesarias principalmente para el tratamiento de enterobacterias productoras de betalactamasa, estafilococos productores de penicilinasas y Bacteroides fragilis productor de betalactamasa. Tabla I. Espectro de Actividad de las Penicilinas. Penicilinas G y V Bacterias grampositivas y cocos gramnegativos Cloxacilina Bacterias grampositivas, excepto enterococos Ampicilina/amoxicilina Bacterias grampositivas y cocos gramnegativos, H. influenzae, E. coli, Proteus mirabilis Amoxicilina-ácido clavulánico Bacterias grampositivas y cocos gramnegativos, H. influenzae, algunas enterobacterias, Bacteroides spp Piperacilina-tazobactam Bacterias grampositivas y cocos gramnegativos, H. influenzae, enterobacterias, P. aeruginosa, A. baumanii, Bacteroides spp Ampicilina-sulbactam Bacterias grampositivas y cocos gramnegativos, H. influenzae, algunas enterobacterias, A. baumanii ENFERMEDADES INFECCIOSAS Y TRATAMIENTO ANTIMICROBIANO 3 BETALACTÁMICOS I: PENICILINAS, AMINOPENICILINAS E INHIBIDORES DE LAS BETALACTAMASAS 04 MECANISMOS DE ACCIÓN DE LOS ANTIBIÓTICOS BETALACTÁMICOS Los betalactámicos son antibióticos que basan su acción terapéutica en la inhibición de la síntesis de la pared bacteriana. La pared bacteriana tanto de las bacterias grampositivas como de las gramnegativas, es una estructura rígida de peptidoglucanos que las protege de la ruptura osmótica. Las bacterias producen en su pared bacteriana unas proteínas denominadas proteínas ligadoras de penicilinas (penicillin-binding-protein) conocidas como PBP que son sobre las que actúan, en general, los antibióticos betalactámicos. La función de la PBP es catalizar una serie de reacciones de transpeptidación y carboxipeptidación necesarias para la síntesis de peptidoglicanos de la pared bacteriana. Por lo tanto, los betalactámicos actúan inhibiendo la síntesis de la pared bacteriana y secundariamente, provocando una lisis de las mismas al perderse la acción estabilizadora antiosmótica de dicha pared. Los betalactámicos también actúan activando la autolisina bacteriana endógena que destruye el peptidoglicano. Son, por tanto, antibióticos bactericidas y su actividad es dependiente del tiempo en que supera la concentración mínima inhibitoria (CMI). La síntesis de la pared bacteriana constituye una etapa crítica en la reproducción de las bacterias y dado que los antibióticos betalactámicos actúan inhibiendo la síntesis de los peptidoglucanos, estos antibióticos sólo actúan frente a bacterias que se están reproduciendo activamente en fase de crecimiento exponencial o logarítmico. La acción mantenida frente a las bacterias grampositivas, (no frente a las gramnegativas) a pesar de que la concentración de antibiótico se encuentre por debajo de la CMI, es lo que se denomina acción postantibiótica que se produce porque los betalactámicos son capaces de unirse de manera persistente a las PBP. No son activos frente a bacterias que carecen de pared celular como micoplasmas y clamidias. ENFERMEDADES INFECCIOSAS Y TRATAMIENTO ANTIMICROBIANO 4 BETALACTÁMICOS I: PENICILINAS, AMINOPENICILINAS E INHIBIDORES DE LAS BETALACTAMASAS 05 INDICACIONES CLÍNICAS 5.1. Peniclinas de primera generación Existen formas comerciales de penicilina por vía oral (penicilina V) que se pueden emplear como tratamiento específico de infecciones por bacterias sensibles (por ejemplo, faringitis estreptocócica), pero su empleo actual en la clínica diaria es muy restringido. Las formas de penicilina de administración intramuscular, especialmente penicilina G benzatina (con liberación sostenida durante semanas), continúa considerándose el tratamiento de elección de la sífilis (excluida la neurosífilis) y puede emplearse como tratamiento de la faringitis estreptocócica y en la profilaxis de la fiebre reumática. Con la penicilina G de administración intravenosa se pueden alcanzar altas concentraciones en plasma, necesarias para atravesar adecuadamente la barrera hematoencefálica para el tratamiento de la neurosífilis. La formulación i.v. puede emplearse en el tratamiento dirigido de algunas infecciones por bacterias sensibles (neumonía neumocócica, meningitis meningocócica o endocarditis estreptocócica) aunque su utilización clínica cada vez es menor. 5.2. Penicilinas con acción antiestafilocócica A nivel clínico, el único antibiótico de este grupo comercializado en España es la cloxacilina. Se trata de penicilinas resistentes a penicilinasas, cuya principal indicación es el tratamiento de infecciones por estafilococos sensibles a oxacilina como Staphylococcus aureus o estafilococos coagulasa negativos. En la actualidad, prácticamente, el 100 % de los estafilococos con relevancia clínica son productores de penicilinasas, por tanto, no se deben emplear de manera empírica las penicilinas de primera generación cuando se sospeche una infección por estafilococos. La infección por Staphylococcus aureus meticilín resistente (SAMR), suele ser una infección adquirida en el ámbito hospitalario. En España existe una gran variabilidad interhospitalaria en cuanto a la incidencia de la infección por SARM pero cada vez es más frecuente, por lo cual, si se sospecha una infección estafilocócica se recomienda iniciar tratamiento empírico con antibióticos activos frente a esta bacteria como Vancomicina o Teicoplanina. Si finalmente se confirma que la cepa aislada es sensible a meticilina, se recomienda cambiar el tratamiento a cloxacilina. Esto se debe a que la actividad antibacteriana intrínseca de este antibiótico frente a S. aureus meticilin sensible es mayor que la de los glucopéptidos. Aunque cloxacilina se encuentra comercializada por vía oral, su biodisponibilidad por vía oral es del 50-70 % y en muchas ocasiones, resulta insuficiente para el tratamiento de infecciones estafilocócicas. ENFERMEDADES INFECCIOSAS Y TRATAMIENTO ANTIMICROBIANO 5 BETALACTÁMICOS I: PENICILINAS, AMINOPENICILINAS E INHIBIDORES DE LAS BETALACTAMASAS 5.3. Aminopeniclinas Se trata del grupo de antibióticos betalactámicos más utilizados en la práctica diaria, por su amplio espectro de acción, su amplio margen de seguridad terapéutica y la diversidad de formulaciones comercializadas. Tanto la amoxicilina como la ampicilina se pueden emplear por vía oral o intravenosa y de manera aislada o en unión a inhibidores de betalactamasas; amoxicilina más ácido clavulánico y ampicilina más sulbactam (sólo i.v.). La biodisponibilidad oral de la amoxicilina es mayor que la de la ampicilina, por lo que se suele preferir amoxicilina, que se emplea habitualmente combinada con ácido clavulánico para el tratamiento de infecciones del tracto respiratorio superior (otitis media, sinusitis) y de neumonías adquiridas en la comunidad que no precisen ingreso hospitalario. También se emplea esta combinación en el tratamiento de las infecciones leves de partes blandas e infecciones no complicadas del tracto urinario. En el caso de las formulaciones intravenosas, la ampicilina se considera el tratamiento de elección de las infecciones por enterococos sensibles a este antibiótico y de la infección por Lysteria monocytogenes. Por vía i.v. se emplea también con más frecuencia, la combinación de amoxicilina con ácido clavulánico para el tratamiento de infecciones graves pero adquiridas en la comunidad y con baja sospecha de infección por Pseudomonas aeruginosa. Se emplea i.v. para infecciones de partes blandas, abdominales, genitourinarias y neumonías adquiridas en la comunidad. Es importante recordar que los betalactámicos carecen de actividad frente a Legionella. ENFERMEDADES INFECCIOSAS Y TRATAMIENTO ANTIMICROBIANO 6 BETALACTÁMICOS I: PENICILINAS, AMINOPENICILINAS E INHIBIDORES DE LAS BETALACTAMASAS 5.4. Carboxipenicilinas y ureidopenicilinas En España se encuentran comercializadas la ticarcilina y la Piperacilina. Éste último se comercializa, exclusivamente, asociado a un inhibidor de betalactamasas, piperacilinatazobactam, que de este grupo es el más empleado en la práctica clínica. Presenta la ventaja frente a las aminopenicilinas de tener actividad frente a Pseudomonas. Suele emplearse en la neumonía nosocomial o que precisa ventilación mecánica, complicaciones infecciosas de cirugía abdominal, ginecológica o urológica y en infecciones de partes blandas como el pie diabético. Su espectro de acción es comparable al de los carbapenemes pero con algunos matices: • En ocasiones Pseudomonas aeruginosa es resistente a piperacilina pero sensibles a carbapenemes. • Piperacilina carece de actividad frente a bacterias productoras de betalactamasas de espectro extendido (BLEE). • En el tratamiento empírico de la neutropenia febril se prefiere, actualmente, el empleo de carbapenemes y no de piperacilina-tazobactam, pues éste antibiótico puede provocar falsos positivos en la técnica de detención de antígeno de Aspergillus en suero (galactomanano). ENFERMEDADES INFECCIOSAS Y TRATAMIENTO ANTIMICROBIANO 7 BETALACTÁMICOS I: PENICILINAS, AMINOPENICILINAS E INHIBIDORES DE LAS BETALACTAMASAS 06 POSOLOGÍA DE LAS DIFERENTES PENICILINAS La posología de los antibióticos depende de: • Factores dependientes del sujeto que va a recibir el tratamiento (edad, función hepática y renal). • La patología infecciosa que se pretende tratar (microorganismo más probable responsable de la infección, gravedad de la misma). • El propio antibiótico (características farmacodinámicas y farmacocinéticas del fármaco). Los betalactámicos son antibióticos cuya acción terapéutica depende, principalmente, del tiempo durante el cual la concentración del antibiótico se encuentra por encima de la CMI necesaria para el tratamiento de una bacteria. Esta característica farmacodinámica, que implica el mantener un nivel suficiente del antibiótico en sangre durante tiempos prolongados, explica, en general, el porqué se trata de fármacos con intervalos cortos de administración (cada 4, 6 u 8 horas). Hay excepciones como en el caso de la penicilina G intramuscular de liberación sostenida o la combinación de amoxicilina-ácido clavulánico 2000/125 mg que permite administrar cada 12 horas el fármaco. PAUTAS DE ADMINISTRACIÓN DE PENICILINAS EN ADULTOS CON FUNCIÓN RENAL Y HEPÁTICA CONSERVADAS Bencilpeniclinas Bencilpenicilinas-penicilina G en sal sódica 1-3 millones UI/2-4 horas Penicilina G procaína 600000-1200000 UI/12-24 horas i.m. Penicilina G benzatina 600000-1200000 UI/1-3 semanas i.m. Fenoximetilpenicilina-penicilina V 0,5-1g/6-8h v.o. Isoxazolilpenicilinas Cloxacilina 0,5-1 g/4-6 horas v.o., 1-2 g/4-6 horas i.v. Aminopenicilinas Amoxicilina 250 mg-1 g/8 horas v.o., 1-2 g/4-6 horas i.v. Ampicilina 0,5-1 g/6-8 horas v.o., 1-2 g/4-6 horas i.v. Carboxipenicilinas Ticarcilina 200-300 mg/kg/d en 4-6 dosis i.m. o i.v. Ureidopenicilinas Ver Piperacilina-tazobactam Penicilinas combinadas con inhibidores de betalactamasas Amoxicilina-ácido clavulánico 250-500-875-2000 mg de amoxicilina (125 mg de ácido clavulánico)/8-12 horas v.o. 1-2 g de amoxicilina (200 mg de ácido clavulánico)/6-8 horas i.v. Ampicilina-sulbactam 1-2 g de ampicilina (0,5-1 g de sulbactam)/6 horas i.v. Piperacilina-tazobactam 2-4 g de piperacilina/250-500 mg de tazobactam)/6-8 horas i.v. Los antibióticos betalactámicos presentan una eliminación por vía urinaria y en caso de insuficiencia renal, se prolonga su vida media y precisan reducción de dosis. En el caso de insuficiencia hepática, en general, no precisan ajuste de dosis, ni siquiera para los de eliminación biliar. ENFERMEDADES INFECCIOSAS Y TRATAMIENTO ANTIMICROBIANO 8 BETALACTÁMICOS I: PENICILINAS, AMINOPENICILINAS E INHIBIDORES DE LAS BETALACTAMASAS 07 MECANISMOS DE RESISTENCIAS BACTERIANA Pocos años después de la comercialización de las penicilinas, empezaron a describirse cepas bacterianas resistentes a este grupo de antibióticos. Desde entonces, el incremento en el porcentaje y en los mecanismos de resistencia de las bacterias frente a los betalactámicos ha sido incesante. Se han descrito cuatro mecanismos de resistencia: • Destrucción de los antibióticos por betalactamasas. • Imposibilidad de los antibióticos de atravesar la membrana externa de las bacterias gramnegativas para alcanzar su objetivo que son las PBP. • Mecanismos de expulsión de los antibióticos a través de la membrana externa de las bacterias gramnegativas. • Baja actividad de unión de los antibióticos a las PBP. 7.1. Betalactamasas Las betalactamasas son enzimas capaces de lisar el anillo betalactámico inactivando la acción del fármaco. Éste es el mecanismo de resistencia más frecuente implicado. Se han descrito cuatro tipos de betalactamasas correspondientes a las clases A, B, C y D. Pueden ser producidas por genes cromosómicos de las bacterias o pueden ser transmitidas de bacteria a bacteria por plásmidos. A su vez, pueden ser constitutivas o inducibles; en este segundo caso, es la presencia de betalactámicos la que hace que aparezcan las betalactamasa (caso de bacterias como Serratia o Enterobacter). Las betalactamasas de las clases A, B y C son en realidad PBP de pequeño tamaño que muestran mayor afinidad por el antibiótico que las PBP que intervienen en la síntesis de la pared bacteriana y que son capaces de hidrolizar el anillo betalactámico de manera irreversible. Las betalactamasas de clase B no son estructuralmente PBP sino enzimas dependientes de zinc, capaces de romper el anillo betalactámico. Las betalactamasas de interés clínico más importantes son las de clase A y C. Las de clase A son capaces de romper el anillo betalactámico de las penicilinas y, en ocasiones, de las cefalosporinas y son inhibibles por el ácido clavulánico. En ocasiones, se producen mutaciones puntuales de las betalactamasas de clase A que aumentan su espectro de inhibición a monobactámicos, cefalosporinas de 3ª generación e, incluso, se hacen resistentes a inhibidores de betalactamasas; se trata de las denominadas betalactamasa de espectro extendido (BLEE). En los últimos años este tipo de betalactamasa se ha convertido en un importante problema clínico, especialmente, en bacterias como E. coli (infecciones de la comunidad) y Klebsiella pneumoniae (infección hospitalaria). La producción de BLEE implica que la bacteria sólo es sensible a los carbapenemes, dentro del grupo de los antibióticos betalactámicos. Muchas de estas bacterias son, además, resistentes a quinolonas, lo que limita el empleo de muchos fármacos en caso de infección grave. ENFERMEDADES INFECCIOSAS Y TRATAMIENTO ANTIMICROBIANO 9 BETALACTÁMICOS I: PENICILINAS, AMINOPENICILINAS E INHIBIDORES DE LAS BETALACTAMASAS Las betalactamasas de clase C son activas frentes a cefalosporinas y no son inhibidas por ácido clavulánico, las de clase B son capaces de hidrolizar el anillo de todos los betalactámicos excepto el de los monobactámicos. 7.2. Impermeabilización de la membrana bacteriana Las bacterias gramnegativas poseen una estructura externa a su pared celular denominada membrana bacteriana. Los betalactámicos son capaces de atravesar dicha membrana a través de unos canales proteicos denominados porinas. En ocasiones se producen mutaciones en las porinas que no permiten el paso de los betalactámicos. 7.3. Mecanismo de expulsión Las bacterias pueden dotarse de las denominadas bombas de expulsión capaces de expulsar a los betalactámicos que habían conseguido atravesar la membrana bacteriana a través de las porinas. 7.4. PBP de baja afinidad por los betalactámicos En este caso, la resistencia se basa en la alteración de las PBP de la bacteria que dificultan su unión al antibiótico y su acción terapéutica. Este mecanismo de resistencia se puede contrarrestar mediante la administración de altas dosis de antibiótico. Es de especial relevancia clínica en el caso de Streptococcus pneumoniae, en el que se han descrito cepas de neumococo productoras de infecciones con CMI cada vez mayores para penicilinas, lo cual exige el empleo de dosis cada vez mayores. ENFERMEDADES INFECCIOSAS Y TRATAMIENTO ANTIMICROBIANO 10 BETALACTÁMICOS I: PENICILINAS, AMINOPENICILINAS E INHIBIDORES DE LAS BETALACTAMASAS 08 EFECTOS SECUNDARIOS Los antibióticos betalactámicos se pueden considerar, en general, como fármacos seguros, con pocas interacciones, pocos efectos secundarios y poca probabilidad de que sean graves. • El efecto secundario más frecuente son las molestias gastrointestinales, especialmente, dispepsia o dolor epigástrico cuando se emplean por vía oral, suele ser un efecto secundario leve y no requiere suspender el fármaco. La presencia de diarrea puede ser un efecto secundario importante y en ocasiones, requiere la retirada del fármaco. Es importante tener en cuenta, sobre todo, en relación con tratamientos prolongados, la posibilidad de que la diarrea no se deba al propio antibiótico sino que sea debida a la toxina de Clostridium difficile. • Algunos efectos secundarios se producen en relación a tratamientos prolongados, de semanas de evolución como los que se requieren en casos de endocarditis u osteomielitis que obliga a realizar controles analíticos periódicos. Vigilar las alteraciones hematológicas como neutropenia, eosinofilia o alteraciones plaquetarias (trombopenia o trombocitosis) que suelen revertir rápidamente tras la retirada del fármaco. También se puede producir, en relación con tratamientos prolongados, la elevación de las transaminasas, especialmente, en el grupo de las penicilinas semisintéticas (cloxacilina) empleadas para el tratamiento de infecciones estafilocócicas. • Otro efecto secundario relacionado con la administración de betalactámicos y especialmente, de Penicilinas es la nefritis intersticial que se caracteriza por un cuadro de elevación de creatinina, eosinofilia, prurito y exantema cutáneo. En ocasiones, el cuadro es incompleto y la sospecha clínica obliga a retirar el antibiótico con lo que suele ser suficiente, aunque puede ser necesaria la administración de esteroides. • La fiebre es otro efecto secundario de los betalactámicos que aparece con más frecuencia cuando la administración es i.v. y durante tiempo prolongado. En ocasiones se acompaña de eosinofilia. La fiebre puede persistir hasta varios días después de retirado el tratamiento. • Un efecto secundario importante, aunque poco frecuente, son las convulsiones que son más frecuentes con penicilinas e imipenem. Los factores de riesgo para su aparición son la patología neurológica previa y la insuficiencia renal. ENFERMEDADES INFECCIOSAS Y TRATAMIENTO ANTIMICROBIANO 11 BETALACTÁMICOS I: PENICILINAS, AMINOPENICILINAS E INHIBIDORES DE LAS BETALACTAMASAS 8.1. Reacciones de hipersensibilidad El efecto secundario más grave son las reacciones de hipersensibilidad que pueden ser potencialmente mortales en algunos casos. Tipo I (reacción anafiláctica inmediata mediada por IgE) Las reacciones más graves son las mediadas por IgE, que pueden ser inmediatas (aparecen en menos de una hora tras la exposición al fármaco) o aceleradas (en las primeras 72 horas). Estas reacciones precisan de una exposición previa al antibiótico responsable para que se produzca la sensibilización y pueden cursar en forma de exantema cutáneo más o menos pruriginoso, laringoespasmo, broncoespasmo o incluso, shock anafiláctico. Pueden ser detectadas mediante las pruebas de reacción cutánea a las penicilinas, la negatividad de estas pruebas, realizada por gente experta, garantiza casi en un 100 % la ausencia de una reacción de hipersensibilidad grave inmediata. Además de las pruebas cutáneas es muy importante la anamnesis para el estudio de una sospecha de reacción alérgica. Hasta el 10 % de la población refiere historia de alergia a Penicilinas, pero cuando se estudian a estos pacientes sólo entre el 10-30 % de estos casos quedan confirmados por reacción cutánea. Tipo II (reacción citotóxica mediada por IgM, IgG), tipo III (enfermedad por inmunocomplejos) y tipo IV (reacción retardada de hipersensibilidad mediada por inmunidad celular) Suelen producir efectos secundarios más allá de las 72 horas tras su administración y, en general, se trata de reacciones menos graves y que se controlan tras la suspensión del fármaco. Idiopáticas Es importante recordar que hay reacciones graves a la administración de betalactámicos (por ejemplo, el Síndrome de Stevens Johnson) no mediados por IgE y por tanto, no reproducibles mediante pruebas cutáneas, en las cuales resulta fundamental la anamnesis detallada de los pacientes para evitar futuras administraciones de los antibióticos responsables. ENFERMEDADES INFECCIOSAS Y TRATAMIENTO ANTIMICROBIANO 12 BETALACTÁMICOS I: PENICILINAS, AMINOPENICILINAS E INHIBIDORES DE LAS BETALACTAMASAS 8.2. Reacciones cruzadas entre los diferentes betalactámicos Es una cuestión de importante relevancia clínica el empleo de otros antibióticos betalactámicos en pacientes con una reacción de hipersensibilidad mediada por IgE frente a penicilinas (pruebas cutáneas positivas). En estos casos, se admite que dada la similitud en la estructura entre las diferentes penicilinas, no se deben administrar ni penicilinas semisintéticas, ni aminopenicilinas, ni carboxi o ureidopenicilinas. Respecto a las cefalosporinas, se han descrito hasta un 10 % de reacciones cruzadas en paciente alérgicos a las penicilinas, por lo que se debe limitar su empleo salvo situaciones de compromiso vital sin otras opciones terapéuticas y bajo estrecha supervisión clínica. Respecto a los carbapenemes, hay estudios que confirman la posibilidad de reacción cutánea en un porcentaje no despreciable de los casos, por lo que se aconseja que si su uso es necesario, se haga una desensibilización previa al carbapenem que se vaya a emplear. Dentro de los antibióticos betalactámicos, el fármaco cuya administración se considera más segura en pacientes alérgicos a penicilina es aztreonam, pero es importante recordar que es un antibiótico sin actividad frente a bacterias grampositivas ni frente a anaerobios. ENFERMEDADES INFECCIOSAS Y TRATAMIENTO ANTIMICROBIANO 13 BETALACTÁMICOS I: PENICILINAS, AMINOPENICILINAS E INHIBIDORES DE LAS BETALACTAMASAS 09 BIBLIOGRAFÍA • López Medrano F, Díaz Pedroche C, San Juan Garrido R. Antibióticos betalactámicos I. Medicine 2006; 9(51): 3344-50. • Gómez Ruiz M.D, Gobernado Serrano M. Generalidades de los antimicrobianos. En Gómez J, Gobernado M, eds. Enfoque clínico de los grandes síndromes infecciosos. 5ª ed. Madrid: Ergon; 2013. p.661-64. • López Medrano F, Díaz Pedroche C, San Juan Garrido R. Antibióticos betalactámicos II. Medicine 2006; 9(52): 3404-11. • Mensa J, Gatell JM, García-Sánchez JE, Letang E, López-Suñé E, Marco F. Guía de terapéutica antimicrobiana 2014. Barcelona. • Chambers Henry F. Penicilinas e inhibidores de las betalactamasas. En Mandell G, Bennet J, Dolin R. Enfermedades Infecciosas principios y práctica. 7ª ed: Philadelphia; Elsevier Churchill Livingstone; 2012. p.309-22. • Wright AJ. The penicillins. Mayo Clin Proc. 1999;74:290-307. ENFERMEDADES INFECCIOSAS Y TRATAMIENTO ANTIMICROBIANO 14
0
0
advertisement
Download
advertisement
Add this document to collection(s)
You can add this document to your study collection(s)
Sign in Available only to authorized usersAdd this document to saved
You can add this document to your saved list
Sign in Available only to authorized users